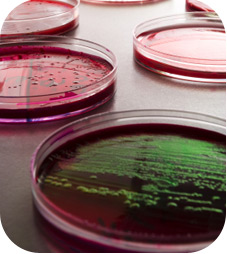

Seguramente no será novedad para quien lea este artículo, que el proceso de resistencia bacteriana hacia los antimicrobianos es un fenómeno natural que nos trae aparejado un grave problema por resolver. Si no hacemos algo hoy, seguramente lo lamentaremos mucho mañana, ya que la pérdida en la eficacia de los antibióticos nos dejará sin cura para muchas patologías. AUTOR: Héctor R. Baigorria. Médico Veterinario. MP 0477. Provincia de Entre Ríos. Argentina.
Acceder al artículo completo en archivo adjunto.

No hay comentarios aún.